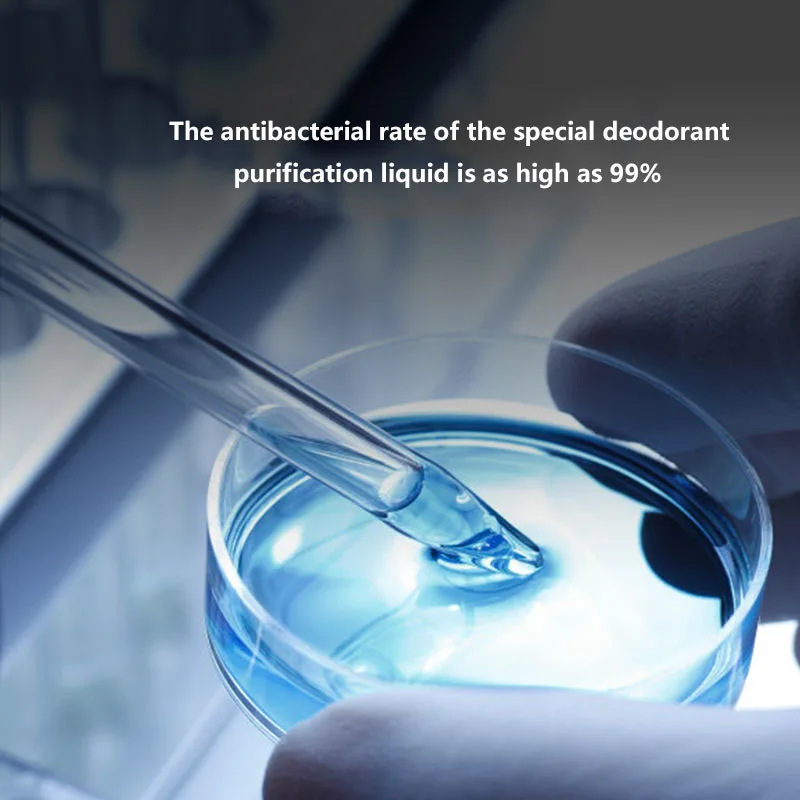

«Intelligent Cleaning Cat Litter Box Deodorizer Spray App Control Air Purifier for Pets Cat Toilet Odor Purifier Pet Supplies B» по лучшей цене на рынке! Всего за 47$ (4465рублей)
vdDmMnVDEqДолго искали Intelligent Cleaning Cat Litter Box Deodorizer Spray App Control Air Purifier for Pets Cat Toilet Odor Purifier Pet Supplies B, но не могли найти? Предоставляем вашему вниманию Intelligent Cleaning Cat Litter Box Deodorizer Spray App Control Air Purifier for Pets Cat Toilet Odor Purifier Pet Supplies B по лучшей цене на рынке!
Перейти на страницу товара в магазине »

Перейти на страницу товара в магазине »

Перейти на страницу товара в магазине »
Перейти на страницу товара в магазине »

Перейти на страницу товара в магазине »

Перейти на страницу товара в магазине »

Перейти на страницу товара в магазине »
Смотри также:
Buy now CREED Men039s Perfume Lasting Fragrance Light Fragrance Fresh Men039s Cologne for 23 right now with delivery 09 02
Buy now Designer new womens handbag Luxurys fashion Brand Bags Famous handbags With shoulder straps Packing bags for 65 right no 09 03
Buy now Georgetown 6s Basketball Shoes Toro Bravo 6 UNC 5s Aqua Infrared Fird Red Oreo Bred Hare Jade Raging Bull 5 Michigan Coo 08 30
Buy now Long Rompers for Women Dressy Tracksuits Two Piece Pants Set Jacket outfits Stripe cold shoulder zipper For Woman Sweat 09 02
Buy now Gradient Twist Three Quarter Sleeve A Line Mini Dress for 13 right now with delivery 08 16 2
Buy now Men Women Designer T Shirts Crew Neck Tops Summer Casual Clothes Fashion Classic Letter Print Clothing Short Sleeve Loos 08 30 4
Buy now Screen Printed Basketball Jakob Poeltl Jersey 25 Lonnie Walker IV 1 Dejounte Murray 5 Keldon Johnson 3 Doug McDermott 17 09 02
Buy now Women Inclined Shoulder Bags Fashion casual Womens Bag Small Handbag Totes High capacity Genuine leather Large volume wh 09 02 5
Buy now Slippers Flat Slides Lady Sandals Casual Shoes Luxury Designer European Style Thick Bottom Comfort Soft High Heel Men Wo 09 02
Buy now Sunglasses Jmm Brand For Women Men Retro Vintage High Quality Fashion Square Acetate Frame PRUDHON Custom Optical Sun Gl 09 02 2
Drug moj vrag moj EHdvard Radzinskij 2012g Skachat knigu chitat onlajn 08 21
Falling For Grace Stella Bagwell g Skachat knigu chitat onlajn 08 27
Kommercheskoe torgovoe pravo Bakalavriat Uchebnik L V Andreeva 2020g Skachat knigu chitat onlajn 08 28
In Ap Stavki Pin Ap Igrat Working Mirror Pin Up 08 28
Kurze Geschichten to go Anni Taint g Skachat knigu chitat onlajn 08 28 2
Muat Turun Pinup Pin Up Casino Pin Up Casino Website 09 03
Nenuzhnyj personazh Andrej Sergeevich Terehov 2016g Skachat knigu chitat onlajn 08 25
Pin Up Ofіcіjnij Bukmeker Pin Up Pin Up Download To Phone 08 20
Pin Ap Kazino Kazino Pin Ap Pin Up Personal 09 04
Pin Up Regisztr%C3%A1ci%C3%B3 Pin Up Registration Igrovye Avtomaty Pin Ap 08 20
Pin Up Casino Inngang Pin Up Casino Website Pin Ap Lichnyj Kabinet 08 22
Pinap Ru Pin Ap Bukmekerskaya Kontora Pin Ap Zerkalo Rabochee 08 27
Prilozhenie Pin Up Pin Ap Stavki Na Sport Pin Up Casino Official 09 04
Severnoe siyanie Vitalij Protov g Skachat knigu chitat onlajn 08 16
Poehtika feminizma YUliya Podlubnova 2021g Skachat knigu chitat onlajn 08 28 2
Razvitie kompozicionnyh umenij studentov hudozhestvennyh fakultetov universiteta S G Ushakova 2014g Skachat knigu chitat onlaj 08 21
Ustrojstvo upravleniya rezervnym pitaniem Evroavtomatika FF Kupit sejchas za 13140 rublej s dostavkoj 09 07
TOM FORD Neroli Portofino 100 Kupit sejchas za 29743 rublej s dostavkoj 08 26
Интересно знать:
Girls Fashion Floral Dress Children Dresses Autumn Girl Cotton Dresses Long Sleeves Children Costume Little Girls Clothing 2 8Y 09 29
120 sht stilus dlya risovaniya koshek i sobak po luchshej cene na rynke Vsego za 29 2755rublej 09 26
3 Supplements with K2 MK7 Vitamin D and K Complex 5000 IU Vitamin D 3 100 Mcg Vitamin K 2 MK 7 Vitamin K2 D3 Capsules po luchs 10 04
License Plate Bracket Turn Signal Bracket License Plate Lamp For Italjet Dragster Fit Italjet Dragster 200 250i 125 400 po lu 10 02
XIN YI Mens high quality t shirt 100 cotton funny fitness banana print casual loose men t shirt o neck male t shirt male tees po 09 26
Bluetooth Compatible Downlight Colorful Spot LED Lamp Recessed Round Light Smart Home Luminaire RGB Dimmable Downlight 220V po l 09 26
New Style Fashion Natural Freshwater Pearl Necklaces Trend Light Luxury Ladies Necklace 18K Real Gold Plated Exquisite Jewelry p 10 05
Kupit 654117 001 kruga G4 Podklyuchenie platy k materinskoj plate polnoe testirovanie kruga podklyucheniya platy po luchshej cen 09 27
Ukrainian National Trident Ukraine Heritage National Day T Shirt Short Sleeve 100 Cotton Casual T shirts Loose Top Size S 3XL po 10 02
AC220V Voltage Regulator 2000W Motor Speed Controller Brushless Electronic Dimmer Temperatur Control Switch for Electric Furnace 10 05
HAS300 SSP54 HAS200 SSP54 HAS150 SSP54 HAS100 SSP54 75S po luchshej cene na rynke Vsego za 28 2660rublej 09 30
PhotoCustom Paint By Number Dog Horse For Adults DIY Frame Picture By Numbers Animals Acrylic Paint On Canvas Home Decor po luch 09 26
ZHenskaya futbolka s kruglym vyrezom svobodnogo pokroya po luchshej cene na rynke Vsego za 6 570rublej 09 26
2022 New Fashion Ladies V Neck Thickened Sweater Warm Knit Winter Dase Top po luchshej cene na rynke Vsego za 24 2280rublej 10 03
Kupit Giyu Brand Tower Of Paris T Shirt Women Tree V neck Tshirt Sail T shirts 3d Painting Shirt Print Womens Clothing Punk Rock 10 05
63117214942 For BMW 5 G30 518d 520d 520i 525d 530i F90 M5 daytime running lights Turn signal Headlight led module Control Unit p 10 05
Natural Colour Jade Dragon Pendant Necklace Fashion Charm Jewellery Chinese Hand Carved Lucky Amulet Accessories Men Women Gifts 10 05
Camiseta con cuello redondo de verano para hombre camisa con diseño de Polonia y Polonia regalo divertido gran oferta 2021 po lu 10 05
Kupit 1PCS New Solid Pure 24Kt 3D Yellow Gold Pendant Women Enamel Heart Bead 01 02g 8mm za 1400rublej 10 05
100 egypt cotton threads Genuine Product cross stitch kits Suite Alisa 2 25 Rose Vase po luchshej cene na rynke Vsego za 10 950r 10 05
SANVI 2PCS A8L Car Bi LEDLaser Projector lens headlight 5500k 66W With AFS framework For BMW X5Audi A4L Auto Headlamp Upgrade po 10 05
Kupit Thickened Sculpture Turntable Model Hand Made Turntable Ceramic Turntable Carving Turntable Pig Iron Turntable Clay Plasti 10 05
20 pcsset Cotton Swab Lipsticks Cigarette Case Portable Lipsticks Waterproof Tattoo Lipstick Liquid Lip Tint Lip Gloss Kit po lu 10 05
Butt Lifter Shaper Lace Butt Lifter Charming Curves Butt Lifting Short 3 Hooks Levanta Gluteos Mujer Skims Kim Kardashian po luc 10 06
38x25mm CNC Machined Solid Aluminum Volume Control Knob For DAC Turntable CD Player Tube Amplifier HIFI Audio Speaker 1PCLot po 10 06
Tie dye Yoga Pants Sport Leggings Women Seamless High Waist Push Up Woman Tights Fitness Workout Leggins Gym Clothing po luchshe 10 06
Girls Princess Polka Dot Dress Kids Wedding Birthday Elegant Party Prom Gown Children Tulle Backless Christmas Costume 4 10 Year 10 06 3
Kupit Rocwickline New Summer and Autumn Womens Dress Sexy Club Solid V Neck Spaghetti Strap Lace Trumpet Mermaid Elegant Robe 10 06
Pure Titanium Mini Bolt Keychain Knife High Hardness Sharp Self Defense Knife Fruit Knife Portable Demolition Express Knife EDC 10 06
OneTigris SCAENA Backpacking Tent 3 Season Easy Setup Instant 2 Person Camping Tent With Outer Tent Tarp For Hiking Trekking po 10 06
Kupit Plus Size Women Elegant Fashion Love Print T shirt Long Sleeve Basic Tees Top 2022 Spring Autumn Loose Vintage Shirts Clot 10 06
Источники вдохновления:
Источник-1 | Источник-2 | xn--s39ak7hbvl7lbn9fs5lvtcdyyqgj0vb.com | jeffreyjjgzu.bloginder.com | embeddedwiki.cs.aau.dk | gornoesp.ru | claytonpdcvn.wikicommunications.com | zghncy.cn | virtuozi.com | i93662uj.bget.ru | lukasexncq.homewikia.com | emihi0216.exblog.jp | co.pinterest.com | pinterest.pt | pl.pinterest.com | yiwu.0579.com | consul-coton.ru | ye23.com | fotolab.ru | nsk.confaelshop.ru | wowthugs.com | world.school2100.com | invitromed.am | metod-kopilka.ru | gongbangunion.com | oplata.info | oplata.info | oplata.info | oplata.info | oplata.info | google.sg |